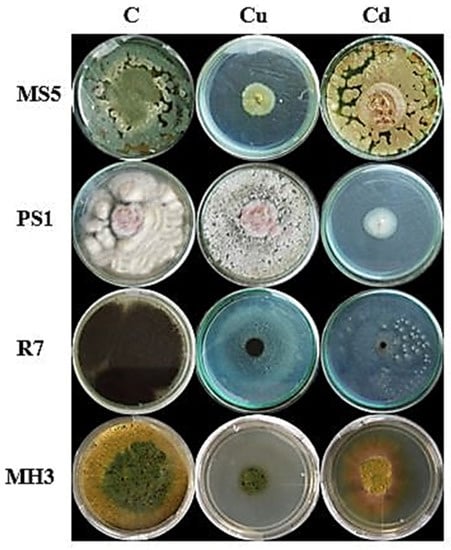

Abstract
Heavy metals contaminate soil and adversely affect plant growth. These soils contain different fungi and bacteria which exhibit metal tolerance and work as bioremediation agents to detoxify polluted soils. In the present study, polluted soil samples were collected to estimate the contamination of copper (Cu) and cadmium (Cd). From this contaminated soil, metal tolerant fungi were isolated and characterized. Copper and cadmium were found in a range of 190.2–300.4 mg/kg and 46.8–56.1 mg/kg, respectively. For the isolation of metal tolerant fungi, soil dilutions were made in water and inoculated on potato dextrose agar (PDA) media. Fungal growth was observed on PDA and successive screening resulted in the isolation of four multi-metal tolerant fungal species, including Penicillim oxalicum, Fusarium solani, Aspergillus niger and Trichoderma harzianum. Sequencing of 18S rRNA genes of isolated fungi also efficiently identified them. To reveal minimum inhibitory concentrations (MIC), these fungi were exposed to increasing concentrations of cadmium and copper chlorides (100 to 1000 ppm) and a variable MIC range of 400 ppm to 1000 ppm was estimated. Based on tolerance index analysis, F. solani was found to be resistant at 1 mM copper, while P. oxalicum was the most tolerant species under cadmium stress. F. solani and P. oxalicum demonstrated the highest biosorption capacity of Cu and Cd, respectively. Both metals negatively affected wheat seedlings in a pot experiment, while the treatment of both F. solani and P. oxalicum positively influenced the germination and growth of wheat. Based on these observations, it could be inferred that F. solani and P. oxalicum can be used for the myco-remediation of Cu and Cd, respectively.
1. Introduction
With the revolution of industry, soil pollution has become one of the most serious environmental issues, in the last few decades. Soil contamination affects food, water and air; consequently, the whole food chain is disturbed. Healthy soils are important to grow food and secure human health. As the food is directly or indirectly produced in soils, contamination-free soils are imperative for the community. Soils are not only important to grow food, but they also mitigate climate change, clean water by filtration, provide moisture to crops and provide anchorage to all crops [1]. Soil pollution alters soil biodiversity by affecting the growth of different microbes, reducing soil organic matter and compacting porosity and soil [2]. Soil pollutants disturb the physiology, chemical composition and biological properties of the soil [3]. Different chemical pesticides, inorganic fertilizers, disease-controlling chemicals, industrial wastes, leather goods, cloth bleaching chemicals, plastics, soft drink tins-cans and carcasses cause soil contamination [4,5]. Some other industrial chemicals like mercury, copper, iron, zinc, lead, cadmium, aluminum, etc. are the sources of soil contamination [6]. The presence of all chemicals is considered pollution if they are accumulated in higher concentrations than required. Humans can contribute to controlling this pollution by safely discarding daily waste and industrial discharge [3].
Metals of different densities are present in the soil. Heavy metals are defined as metals that have more than 6 mg/m3 (or 5 g/cc) density [7]. Heavy metals not only cause toxicity but also cause the deficiency of micronutrient cations [8]. Heavy metals can stay in the soil for a few days to hundreds of years [9] and disturb the soil ecosystem and the structure and texture of soil [10]. Heavy metals can persist in water and their eradication has become a great challenge [11]. Different industrial and human activities result in the transfer of heavy metals to the soil [12]. Natural geological sources have been reported to cause soil pollution of natural soil [13]. It has become imperative to find different remediation methods to control soil contamination [14]. Scientists use both methods according to the requirement of the site [15]. Various physical, chemical and biological approaches are being used to remediate polluted soils. By physical remediation, people do replacement and thermal treatment of soil [16]. These techniques are more suitable for seriously contaminated soils and work well in heavily polluted areas [17]. Chemical remediation involved the use of chemical reagents to remove contaminants [18]. Different chemicals are used for the flushing and washing of contaminated soils [17]. Solidification is another way of remediation, in which contaminated soils are mixed with reagents and these reagents stop or inhibit the mobility of heavy metals [19]. Many studies have reported successful immobilization of metals in polluted soils by using different chemicals [20,21]. For chemical washing of soil, scientists have used water and different chelating agents [22,23] like Ethylene diamine tetra acetic acid (EDTA) [24]. EDTA has high metal removal ability and does not affect useful microorganisms of soil [25].
Biological remediation or bioremediation is a modern technique of using the natural mechanisms of plants and microorganisms to remove heavy metals [26]. Bioremediation is emerging as the best technology due to its eco-friendly and cost-effective nature [27]. Bioremediation has been reported to reduce costs by 50–65% when compared with other physical and chemical methods [28]. In bioremediation, different microorganisms and/or plants are used, and they physically remove metals from the soil. Among microorganisms, different fungi, bacteria, and algae are used [29]. Precipitation and biosorption are being considered the major mechanisms of bioremediation [27]. Many studies have also suggested the application of plants and microorganisms, in combination, for soil remediation [30]. Microorganisms can take pollutants as nutrients, and they can survive well in polluted environments. They usually have the absorptive or accumulative ability and attach contaminants to their surface. Soil microorganisms can also mobilize and immobilize metal cations and change their plant absorption ability [31]. The metal tolerance ability of microorganisms makes them a useful candidate for the remediation of polluted soils [17]. The use of fungi for the remediation of polluted soils is termed mycoremediation. Scientists have described the involvement of different pigmented molecules like melanin in the tolerance of fungi [32,33]. Fungi use this property, and they can bind heavy metals and remove them from wastewaters and soils [34]. Many scientists have reported the multi-metal tolerance properties of fungi [35]. Fungi can also produce intra-cellular as well as extracellular enzymes to tolerate toxic metals [36]. Detailed studies have revealed the metal tolerance potential of different species like Penicillium, Trichoderma, Aspergillus, Pseudomonas, Sporophyticus, Bacillus, Phanerochaete, etc. These all species play important role in the removal of different heavy metals from the soil [10].
The present study was designed for the collection and analysis of heavy metal contaminated industrial soil of Islamabad Capital Territory (ICT). This is the first effort to explore metal contamination in the industrial zone of the capital city. To make bioinoculants, the pathogens were isolated from these soils and tested for metal tolerance in wheat. Isolated novel strains were further recommended for their utilization to successfully grow wheat crops in metal-contaminated soils of Islamabad and adjacent areas. Wheat is a staple food in Pakistan, and these bioinoculants can provide a sustainable solution to grow wheat in cadmium and copper contaminated soils.
2. Material and Methods
2.1. Reagents and Instruments
All chemicals used in this study were of analytical reagent (AR) grade and were purchased from Sigma Aldrich (Taufkirchen, Germany). Instruments used for the determination of different parameters are mentioned in their respective descriptions.
2.2. Soil Sample Collection and Processing
Five different soil samples (IS1, IS2, IS3, IS4 and IS5) were collected from I-9 Industrial area, Islamabad (33°39′43.2″ N and 73°2′49.2″ E). Samples were collected at the depth of 0~20 cm in clean polythene bags, labeled and transferred to the laboratory in ice containers, within one hour. Using mortar and pestle, collected soil samples were crushed and dried. Before further use, the soil samples were cleaned by passing through 2-millimeter sieve and stored at room temperature.
2.3. Physiochemical Properties of Soil Samples
Processed soil samples were used for the determination of different physiochemical properties. For the measurement of soil organic matter, a standard protocol was followed [37]. Air-dried soil was weighed (2 g) was transferred to the flask. Carefully, concentrated H2SO4 (20 mL) was added to the flask. In this mixture 1 N K2Cr2O7 (10 mL), water and ortho-phosphoric acid (10 mL) were also transferred. After 30 min, few drops of indicator diphenylamine were also added. The titration of mixture was performed against 0.5 N Mohr’s control.
For the determination of soil pH, a standard protocol was followed [38]. For this purpose, soil was mixed in water (1:2 ratio) and pH of the suspension was measured by using pH meter (OrionTM Russell RL060P, Thermo Scientific–Indonesia). Electrical conductivity was determined using an optimized protocol [38]. Soil of each sample was mixed separately in deionized water in 1:2 ratio. Stirring of suspension was performed for 8–10 min until uniform turbidity. EC of these soil mixtures was measured using electrical conductivity meter (DOS-11 AW, MXBAOHENG, Hangzhou, China) and described in deciSiemens per meter. For nutrient analysis, different macronutrients including Nitrogen (N), Potassium (K) and Phosphorus (P) were measured [39].
For heavy metals analysis, 1 g of each soil sample was taken in porcelain crucibles and 10 mL Aqua regia solution was added to these crucibles and placed in water bath at 65 °C. After 6 h, the supernatant of heated solution was taken and carefully passed through the filter paper. Distilled water was added, and the volume of solution was increased to 25 mL. Using atomic absorption spectrometer (AA320N, Wincom Company Ltd., Changsha, China), the concentrations of heavy metals were determined.
In this study, three major pollution indices including contamination factor (CF), geo-accumulation index (Igeo), and pollution index (PI) were determined. CF was determined by the following equation [40] and the background values were obtained from previous studies [41]:
CF = metal content in the sampling site/metal content in the background environment
To determine the level of heavy metal pollution in the soil samples, Igeo was determined by the following formula [42]:
where Cn represents the concentration of the heavy metal in sampling sites and Bn represents the concentration of the heavy metal in background environment. For an explanation of these results, pollution categories were used [43].
Igeo = log2 Cn/1.5 × Bn
PI of collected soil samples was determined by the following equation [44].
where CFav represents average CF value and CFmax represents maximum CF value.
Serial dilution method was used to isolate fungal strains on potato dextrose agar (PDA) media. To restrict bacterial growth, streptomycin (15 mg L−1) and chloramphenicol (50 mg L−1) were supplemented in PDA media, and it was amended with 100 mg/L of Cd and Cu. Each soil sample (1 g) was transferred to autoclaved water (100 mL) and diluted (up to 10−3). In the petri plates, 0.1 mL of each dilution was spread and incubated at 25 °C. Petri plates were regularly observed, and fungal mycelia were sub-cultured on fresh PDA plates. Fungal samples were purified and stored at 4 °C.
2.4. Screening and Identification of Selected Fungal Strains
Fungi were grown on Cd and Cu supplemented media, and the identification of multi-metal tolerant fungi was performed on the basis of their growth morphology, microscopic appearance and sequence analyses.
2.4.1. Morphological Identification
Morphological identification was done by observing fungal growth on PDA media. The petri plates were observed from both sides and characteristic features were noted.
2.4.2. Microscopic Identification
Clean slide was taken and a drop of lactophenol blue was placed on it. Minute plug of fungal mycelia was picked using inoculating needle and was shifted to the lactophenol blue on glass slide. With the help of two sterile dissecting needles, fungus was teased apart and spread, gently. A drop of lactic acid was placed on mycelia and covered with a cover slip, avoiding air bubbles. Slides were examined under compound microscope.
2.4.3. Molecular Identification
For the amplification of 18S ribosomal RNA gene, the extraction of fungal DNA was performed using cetyltrimethyl ammonium bromide (CTAB) method [45]. In a polymerase chain reaction (PCR), forward and reverse primers were used to amplify 18S ribosomal RNA gene. The reaction mixture for PCR was comprised of genomic DNA (1 µL), Taq polymerase enzyme (1.5 µL), dNTPs (5 µL), 10× polymerase buffers and each primer (1 μL). The thermocycler was set on 94 °C for 5 min, followed by 32 cycles of 94 °C for 40 s, 57 °C for 40 s, and 72 °C for 40 s. The sequencing of PCR product was performed, and the resultant sequence was explored in basic local alignment search tool (BLAST) of NCBI database (https://blast.ncbi.nlm.nih.gov/Blast.cgi, accessed on 21 March 2022).
2.5. Minimum Inhibitory Concentration
The estimation of minimum concentration of metal that could inhibit fungal growth was determined by using dilution method. For this purpose, 100 to 1000 ppm concentrations of Cd and Cu salts were added to PDA media. In control PDA media, no metal was added. To check the growth of isolated fungi, all PDA plates were inoculated with isolated fungi in three replicates. Plates were incubated at 24 ± 2 °C for one week and minimum inhibitory concentration of both metals was determined.
2.6. Metal Tolerance Index
Metal tolerance index (TI) of selected fungi was determined by comparing the growth of fungi on metal supplemented plates and control plates. For this analysis, PDA media were supplemented with 1 mM Cd and 1 mM Cu salts, while PDA media with no salt, served as control. Isolated fungi were placed on these plates and incubated at 24 ± 2 °C for one week. Fungal colony diameter was measured, and TI was determined by the following formula:
TI = Fungal growth in the presence of metal/Fungal growth in the absence of metal
2.7. Biosorption Capacity of Isolated Fungi
For this analysis, different quantities of cadmium and copper salts (50, 100, 150 and 200 mg/L) were added to potato dextrose broth (PDB). Selected fungi were inoculated in these salts amended media. These fungi-inoculated media were grown at different pH (3.0–8.0) and temperature (20 °C, 28 °C and 37 °C) conditions. After one week of incubation, fungal mycelia were filtered and oven dried. The obtained dry fungal biomass was placed in electric furnace at 440 ± 10 °C for 3 days. After the conversion of fungal biomass into whitish ash, it was suspended in conc. HNO3. Then H2SO4 was added and diluted with water. The quantity of Cd and Cu was measured by using atomic absorption spectrophotometer.
where Qe is the amount of adsorbed metal ions of the absorbent (mg/g), Ci is the initial metal concentration in the solution (mg/L), Ce is the equilibrium concentration of metal ion in the solution (mg/L), V is the volume of the medium in liter and m is the amount of the biomass in g.
Qe = (Ci − Ce)V/m
2.8. Seed Germination Assay
The PS1 (F. solani) and MS5 (P. oxalicum) strains were grown in potato dextrose broth for 5 days at 25–27 °C and the hyphal fragment suspension of PS1 and MS5 was diluted with sterilized distilled water to OD 600 = 2.0. Wheat seeds were surface sterilized with 1% hypochlorite sodium solution (for 3 min) and 70% ethanol (for 2 min) and rinsed with distilled water. Sterilized seeds were immersed at 25–27 °C for 18 h in hyphal culture suspensions. Seeds soaked in distilled water were used as control treatment. After 18 h, the seeds were air-dried. Five treated and control seeds were put separately in individual sterile petri dishes and 3 mL of solutions containing 0 and 0.5 mM Cd and Cu, respectively, were added to the petri dishes. Seven different treatments were germinated in an incubator at 24 °C.
2.9. Germination Rate
Seeds were said to be germinated when the 2-millimeter radical emerged from the seed coat. The germination percentage was recorded after every 24 h using the following formula of Manmathan and Lapitan (2013):
Germination rate = germinated seeds ÷ total seeds × 100
2.10. Root and Shoot Length
After 10 days, lengths of freshly harvested shoots and roots of wheat plants were measured with the help of measuring tape.
2.11. Statistical Analysis
All experiments were performed in triplicates unless otherwise mentioned. Means of all treatments and standard errors were determined using Microsoft Excel. Statistix 8.1 was used to perform analysis of variance (ANOVA) on the collected data. The statistical significance of treatment mean values was determined using the HSD value of p < 0.05.
3. Results
3.1. Physiochemical Properties of Soil
Different physiochemical properties revealed the nature and composition of collected soil samples. The pH of the industrial soil sample was found in the range of 8.25–7.55. EC values were obtained in a range of 2.17 to 2.60 dS/m. The soil texture was sandy loamy and contained a minor amount of organic matter (Table 1). Nutrient analysis revealed a higher concentration of potassium in all salt samples. Among all tested soil samples, sample IS5 exhibited the highest presence of all nutrients (Table 2). All the tested soil samples were found to be heavily contaminated with Cu and Cd. However, the concentration of Zn and Pb were lower than the prescribed limit (Table 3).

Table 1.
Physiochemical properties of contaminated soil samples.

Table 2.
Nutrient analysis of industrial soil samples.

Table 3.
Heavy metals concentrations of contaminated soil samples.
3.2. Contamination Factor (CF) and Geo-Accumulation Index (Igeo)
CF analysis revealed a very high concentration of Cd and Cu while the low contamination of Zn and very low contamination of Pb were recorded (Figure 1). The results of Igeo depicted no pollution of Pb, moderate pollution of Zn and Cu and strong pollution of Cd (Figure 2).

Figure 1.
Contamination factor of different heavy metals from industrial soil. Bars indicate standard errors of the mean.

Figure 2.
Geo accumulations of different heavy metals from industrial soil. Bars indicate standard errors of the mean.
3.3. Pollution Index (PI)
Pollution index of tested samples was more than 3, which indicated severely polluted soil of the study area (Table 4).

Table 4.
Pollution index of individual heavy metals in contaminated soil samples.
3.4. Isolation and Screening of Fungi from Soil Sample
Variable numbers of fungi were isolated from different soil samples. Maximum microbes were isolated from soil sample IS4. This sample showed low heavy metal contamination. Soil sample IS5 exhibited the most metal contamination and very few microbes could be isolated from it. All soil samples were heavily contaminated with Cd and Cu. Screening of fungal strains under Cd and Cu stress revealed that most of the isolated fungi were tolerant to one metal only. Some strains like MS5, PS1, R7 and MH3 showed tolerance against both Cd and Cu.
3.5. Macroscopic and Microscopic Identification of Isolated Fungi
After 5–7 days of incubation, colony morphology was observed from the front and backside of plates. Microscopic photographs of the selected fungal strains at 40× magnification also helped us to distinguish and identify these fungi (Figure 3). Detailed macroscopic and microscopic characteristics of the selected fungi are presented in Table 5.

Figure 3.
Microscopic photographs of MS5 (Penicillium oxalicum), PS1 (Fusarium solani), R7 (Aspergillus niger) and MH3 (Trichoderma harzianum) at 40× magnification.

Table 5.
Macroscopic and microscopic characteristics of metal tolerant fungal strains.
3.6. Molecular Identification
Identification of metal tolerant fungi was successfully accomplished by sequencing their 18S ribosomal RNA gene. Isolated strains MS5, PS1, R7 and MH3 were identified as Penicillium oxalicum (KF150220), Fusarium solani (MT560378), Aspergillus niger (MT303078) and Tichoderma harzianum (MT626718), respectively.
3.7. Minimum Inhibitory Concentrations (MIC) and Tolerance Index (TI)
Different fungi exhibited variable MICs and MS5 showed the most resilience against both metals (Table 6). Tolerance index revealed the best tolerance of Cd by MS5 while PS1 exhibited the highest tolerance against copper (Figure 4).

Table 6.
MIC of heavy metal resistant fungal strains.

Figure 4.
Tolerance index of selected fungal strains. MS5 = P. oxalicum, PS1 = F. solani, R7 = A. niger and MH3 = T. harzianum. Bars indicate standard errors of mean.
3.8. Morphological Variations
Metal exposure resulted in changing the morphology of fungal colonies and these changes were more prominent at higher metal concentrations (Figure 5). Under Cu stress, colonies of MS5 strain appeared dirty green and under Cd stress, these colonies were yellowish green in color. Strain PS1 showed small and separated colonies on Cu amended media, while these colonies were creamy in Cd amended media. In the presence Cu, strain R7 formed a black colony in the center with whitish mycelia from the edges. In Cd-amended media, R7 colonies were whitish in color and were distributed in the plate. Under the exposure of Cu, the color of MH3 did not change much but suffered a strong growth inhibition. This growth inhibition could also be observed under Cd stress.
Figure 5.
Growth of fungi on different metal supplemented media. Four isolates including MS5 (P. oxalicum), PS1 (F. solani), R7 (A. niger) and MH3 (T. harzianum) were grown on control media (C), copper supplemented media (Cu) and cadmium supplemented media (Cd).
3.9. Biosorption Capacity
Metal concentration, temperature and pH affected biosoption capacity of isolated fungi (Figure 6). Overall, biosorption of both metals was increased at higher metal concentrations, indicating more availability of metals to all fungi. Temperature also affected the biosoption capacity of all isolated fungi. Maximum biosorption of both metals was observed at 28 °C and pH 6. These results indicate that all fungi perform well at their optimum growth conditions. Moreover, slightly acidic and more basic condition decrease biosoption capacity of isolated fungi. Fungi showed maximum biosorption of both metals at slightly basic environmental conditions.

Figure 6.
Biosorption of metal ions by various fungal isolates was affected by metal concentrations (A), temperature (B) and pH (C). In this analysis for fungal strains viz. MS5 (P. oxalicum), PS1 (F. solani), R7 (A. niger) and MH3 (T. harzianum) were used. Bars indicate standard errors of mean.
3.10. Seed Germination Assay
The germination of wheat seeds was negatively affected by rising Cd and Cu concentration (Figure 7 and Figure 8). The germination rate was higher for seeds treated with PS1 and MS5 than for seeds treated with 0.5 mM of Cd and Cu concentration (p > 0.05). The germination rate of seeds was found to be greater than the control rate in the fungal-inoculated treatments. The germination of seeds has been adversely affected by growing concentrations of metals. At 0.5 mM Cd and Cu concentrations, the minimum germination rate was observed in the control treatment. Increases in the germination rate have been observed in inoculated fungal treatments.

Figure 7.
Effect of different treatments on wheat seedlings. (A) Uninoculated seedlings without stress, (B) Seedlings under the influence of PS1 (F. solani), (C) Seedlings under the influence of MS5 (P. oxalicum), (D) Seedlings under 0.5 mM Cu, (E) Seedlings under 0.5 mM Cd, (F) Seedling under the influence of PS1 (F. solani) and 0.5 mM Cu, (G) Seedling under the influence of MS5 (P. oxalicum) and 0.5 mM Cd.

Figure 8.
Influence of various treatments on seed germination. (T1) Uninoculated seedlings without stress, (T2) Seedlings under the influence of PS1 (F. solani), (T3) Seedlings under the influence of MS5 (P. oxalicum), (T4) Seedlings under 0.5 mM Cu, (T5) Seedlings under 0.5 mM Cd, (T6) Seedling under the influence of PS1 (F. solani) and 0.5 mM Cu, (T7) Seedling under the influence of MS5 (P. oxalicum) and 0.5 mM Cd.
3.11. Root and Shoot Assay
Water-treated wheat seeds demonstrated shorter root lengths than seeds treated with PS1 and MS5 (Figure 9). At a concentration of 0 mM Cd, fungal inoculation greatly enhanced the growth attributes of wheat seedlings. Root length and shoot length of PSI and MS5 treated plants decreased at 0.5 mM Cd and Cu concentrations, but it was still better than control treatment (Figure 10). The results showed that the root and shoot length of plants was increased in all treatments (under stressed and non-stressed conditions) by the application of metal resistant fungi and decreased under the condition of disease stress.

Figure 9.
Influence of various treatments on shoot length. (T1) Uninoculated seedlings without stress, (T2) Seedlings under the influence of PS1 (F. solani), (T3) Seedlings under the influence of MS5 (P. oxalicum), (T4) Seedlings under 0.5 mM Cu, (T5) Seedlings under 0.5 mM Cd, (T6) Seedling under the influence of PS1 (F. solani) and 0.5 mM Cu, (T7) Seedling under the influence of MS5 (P. oxalicum) and 0.5 mM Cd.

Figure 10.
Influence of various treatments on root length. (T1) Uninoculated seedlings without stress, (T2) Seedlings under the influence of PS1 (F. solani), (T3) Seedlings under the influence of MS5 (P. oxalicum), (T4) Seedlings under 0.5 mM Cu, (T5) Seedlings under 0.5 mM Cd, (T6) Seedling under the influence of PS1 (F. solani) and 0.5 mM Cu, (T7) Seedling under the influence of MS5 (P. oxalicum) and 0.5 mM Cd.
4. Discussion
Toxic metals affect the diversity of the soil microbes and make them resistant against different metal stresses [46]. These resistant microbes can be used to improve plant growth under metal stress conditions. In the present study, potentially resistant fungi have been isolated and characterized. Fungi have been widely used for the remediation of toxic metals from the soil [47]. Fungi are also useful for the adhesion of inorganic compounds [48]. Microbial cells interact with these metals through physiochemical mechanisms and these interactions are then responsible for important events like mineralization, biogeochemical cycles and deposition of certain metals [49]. These results signify the importance of fungi as biocontrol agents. The results of soil analysis depicted that soil was heavily contaminated with cadmium and copper. Fungal strains showing tolerance towards both metals were isolated and characterized. Molecular characterization identified these isolated strains as Penicillium oxalicum, Fusarium solani, Aspergillus niger and Trichoderma harzianum. Both selected fungi (P. oxalicum and F. solani) positively influenced the growth of wheat seedlings under both metal stressed and normal conditions. These results suggested the application of these fungi for the remediation of both Cd and Cu.
In the current study, most of the metal tolerant fungal strains exhibited changes in morphology by changing the color of mycelia and mycelial pattern. A similar observation on the morphological changes of fungal culture was described earlier [50]. These morphological changes describe the detoxification mechanisms. Changes in mycelial pattern enable fungi to tolerate immense metal stress and the color changes describe the adaptability of fungi against different metal stresses [36].
Soil quality is affected by a variety of factors. Among these, soil enzyme activities influence the concentration of different metals in the soil [51,52]. Results of this study depicted that the increasing metal concentration also improves biosorption capacity of fungus. Previous studies have also verified that the same higher concentrations of metal help us to understand the biosorption capacity of metal tolerant fungi [53]. Maximum biosorption capacity of isolated fungi was observed at moderate temperature (28 °C). Temperature’s extremes result in decreased metabolic rates of microbes and degrade their transport proteins [54]. Results of this study also described the effect of pH on biosorption capacity. Tu et al. [55] also observed maximum biosorption of metals at pH 6. These results declare that a slight acidic pH can increase biosorption potential of fungi, being used for the bioremediation of contaminated soils.
Along with other techniques [56], heavy metal tolerant fungi can also be used as useful agents for the bioremediation of contaminated soils. They can absorb these metals from soil and help plants to grow under these toxic conditions [57]. This study has also suggested the use of metal tolerant fungi to efficiently adsorb Cu and Cd and influence the growth of wheat under the stress of these metals.
5. Conclusions
Findings of this study revealed that the industrial soil of Islamabad capital territory is highly contaminated with Cd and Cu. This soil also contains few metal-tolerant fungi, which were successfully isolated and characterized. Among these, novel strains of F. solani and P. oxalicum exhibited enhanced tolerance against Cu and Cd metals and they can be used for the bioremediation of contaminated soils. The use of fungi as biocontrol agents can provide us a practical solution to reduce soil pollution and increase the availability of land to produce useful crops.
Author Contributions
M.A. (Mahnoor Akbarand) conducted all experiments and collected data; A.M.E.-S., S.S., E.A.M. and H.O.E. compiled and organized data; F.A., B.u.D., U.H., M.A. (Musrat Ali) and H.S. prepared soil samples for analyses. M.A. (Maryam Anar), A.K., K.T., J.A. and M.S.Z. worked on isolation of strains; H.J.C. supervised writeup and M.F.H.M. designed and supervised the whole study. All authors have read and agreed to the published version of the manuscript.
Funding
This work was financially supported by Research Supporting Project (RSP-2021/118), King Saud University, Riyadh, Saudi Arabia, and University research fund (URF-19), Quaid-i-Azam University, Islamabad.
Institutional Review Board Statement
This study does not involve humans and other animals and the statement is not applicable.
Informed Consent Statement
Not applicable.
Data Availability Statement
Study did not report any data.
Acknowledgments
The authors extend their deep appreciation to the Researchers Supporting Project number (RSP-2021/118), King Saud University, Riyadh, Saudi Arabia. We are thankful to Metropolitan Corporation Islamabad for helping and guiding us to collect soil samples from I-9 industrial area, Islamabad, Pakistan.
Conflicts of Interest
The authors declare no conflict of interest.
References
- Gavrilescu, M. Water, soil, and plants interactions in a threatened environment. Water 2021, 13, 2746. [Google Scholar] [CrossRef]
- Liaquat, F.; Haroon, U.; Munis, M.F.H.; Arif, S.; Khizar, M.; Ali, W.; Shengquan, C.; Qunlu, L. Efficient recovery of metal tolerant fungi from the soil of industrial area and determination of their biosorption capacity. Environ. Technol. Innov. 2021, 21, 101237. [Google Scholar] [CrossRef]
- Rajkumar, M.; Freitas, H. Influence of metal resistant-plant growth-promoting bacteria on the growth of Ricinus communis in soil contaminated with heavy metals. Chemosphere 2008, 71, 834–842. [Google Scholar] [CrossRef] [PubMed] [Green Version]
- Bungau, S.; Behl, T.; Aleya, L.; Bourgeade, P.; Aloui-Sossé, B.; Purza, A.L.; Abid, A.; Samuel, A.D. Expatiating the impact of anthropogenic aspects and climatic factors on long-term soil monitoring and management. Environ. Sci. Pollut. Res. 2021, 28, 30528–30550. [Google Scholar] [CrossRef]
- Lashen, Z.M.; Shams, M.S.; El-Sheshtawy, H.S.; Slaný, M.; Antoniadis, V.; Yang, X.; Sharma, G.; Rinklebe, J.; Shaheen, S.M.; Elmahdy, S.M. Remediation of Cd and Cu contaminated water and soil using novel nanomaterials derived from sugar beet processing-and clay brick factory-solid wastes. J. Hazard. Mater. 2022, 428, 128205. [Google Scholar] [CrossRef]
- Samuel, A.D.; Bungau, S.; Tit, D.M.; Melinte, C.E.; Purza, L.; Badea, G.E. Effects of long term application of organic and mineral fertilizers on soil enzymes. Rev. Chim. 2018, 69, 2608–2612. [Google Scholar] [CrossRef]
- Takhelmayum, G.; Savitha, A.L.; Krishna, G. Laboratory study on soil stabilization using fly ash mixtures. Int. J. Eng. Sci. Innov. Technol. 2013, 2, 477–482. [Google Scholar]
- Bansal, R.; Pfeiffer, S.E. Novel stage in the oligodendrocyte lineage defined by reactivity of progenitors with R-mAb prior to O1 anti-galactocerebroside. J. Neurosci. Res. 1992, 32, 309–316. [Google Scholar] [CrossRef]
- Kabata-Pendias, A. Agricultural problems related to excessive trace metal contents of soils. In Heavy Metals; Springer: Berlin/Heidelberg, Germany, 1995; pp. 3–18. [Google Scholar]
- Garland, J.L.; Mills, A.L. Classification and characterization of heterotrophic microbial communities on the basis of patterns of community-level sole-carbon-source utilization. Appl. Environ. Microbiol. 1991, 57, 2351–2359. [Google Scholar] [CrossRef] [Green Version]
- Congeevaram, S.; Dhanarani, S.; Park, J.; Dexilin, M.; Thamaraiselvi, K. Biosorption of chromium and nickel by heavy metal resistant fungal and bacterial isolates. J. Hazard. Mater. 2006, 146, 270–277. [Google Scholar] [CrossRef]
- Dixit, R.; Malaviya, D.; Pandiyan, K.; Singh, U.B.; Sahu, A.; Shukla, R.; Paul, D. Bioremediation of heavy metals from soil and aquatic environment: An overview of principles and criteria of fundamental processes. Sustainability 2015, 7, 2189–2212. [Google Scholar] [CrossRef] [Green Version]
- Presser, H.B. Employment schedules among dual-earner spouses and the division of household labor by gender. Am. Sociol. Rev. 1994, 59, 348–364. [Google Scholar] [CrossRef]
- Song, B.; Zeng, G.; Gong, J.; Liang, J.; Xu, P.; Liu, Z.; Ye, S. Evaluation methods for assessing effectiveness of in situ remediation of soil and sediment contaminated with organic pollutants and heavy metals. Environ. Int. 2017, 105, 43–55. [Google Scholar] [CrossRef] [PubMed]
- Mulligan, C.N.; Yong, R.N.; Gibbs, B.F. Remediation technologies for metal-contaminated soils and groundwater: An evaluation. Eng. Geol. 2001, 60, 193–207. [Google Scholar] [CrossRef]
- Yao, Y.; Gao, B.; Chen, J.; Zhang, M.; Inyang, M.; Li, Y.; Yang, L. Engineered carbon (biochar) prepared by direct pyrolysis of Mg-accumulated tomato tissues: Characterization and phosphate removal potential. Bioresour. Technol. 2012, 138, 8–13. [Google Scholar] [CrossRef]
- Mehmood, S.; Ahmed, W.; Alatalo, J.M.; Mahmood, M.; Imtiaz, M.; Ditta, A.; Ali, E.F.; Abdelrahman, H.; Slaný, M.; Antoniadis, V.; et al. Herbal plants-and rice straw-derived biochars reduced metal mobilization in fishpond sediments and improved their potential as fertilizers. Sci. Total Environ. 2022, 826, 154043. [Google Scholar] [CrossRef]
- Song, W.; Gao, B.; Xu, X.; Xing, L.; Han, S.; Duan, P.; Jia, R. Adsorption-desorption behavior of magnetic amine/Fe3O4 functionalized biopolymer resin towards anionic dyes from wastewater. Bioresour. Technol. 2016, 210, 123–130. [Google Scholar] [CrossRef]
- Hodson, A.; Tranter, M.; Vatne, G. Contemporary rates of chemical denudation and atmospheric CO2 sequestration in glacier basins: An Arctic perspective. Earth Surf. Process. Landf. 2000, 25, 1447–1471. [Google Scholar] [CrossRef]
- Lim, J.W.; Chen, C.L.; Ho, I.J.; Wang, J.Y. Study of microbial community and biodegradation efficiency for single-and two-phase anaerobic co-digestion of brown water and food waste. Bioresour. Technol. 2013, 147, 193–201. [Google Scholar] [CrossRef]
- Soares, H.M.V.M.; Boaventura, R.A.R.; Machado, A.A.S.C.; Da-Silva, J.E. Sediments as monitors of heavy metal contamination in the Ave River basin (Portugal): Multivariate analysis of data. Environ. Pollut. 1999, 105, 311–323. [Google Scholar] [CrossRef]
- Dermont, G.; Bergeron, M.; Mercier, G.; Richer-Laflèche, M. Soil washing for metal removal: A review of physical/chemical technologies and field applications. J. Hazard. Mater. 2008, 152, 1–31. [Google Scholar] [CrossRef] [PubMed]
- Jiang, M.; Griffin, W.M.; Hendrickson, C.; Jaramillo, P.; Van Briesen, J.; Venkatesh, A. Life cycle greenhouse gas emissions of Marcellus shale gas. Environ. Res. Lett. 2011, 6, 034014. [Google Scholar] [CrossRef]
- Leštan, D.; Luo, C.L.; Li, X.D. The use of chelating agents in the remediation of metal-contaminated soils: A review. Environ. Pollut. 2008, 53, 3–13. [Google Scholar] [CrossRef] [PubMed] [Green Version]
- Qiao, M.; Bai, Y.; Cao, W.; Huo, Y.; Zhao, X.; Liu, D.; Li, Z. Impact of secondary effluent from wastewater treatment plants on urban rivers: Polycyclic aromatic hydrocarbons and derivatives. Chemosphere 2017, 211, 185–191. [Google Scholar] [CrossRef]
- Ayangbenro, A.S.; Babalola, O.O. A new strategy for heavy metal polluted environments a review of microbial biosorbents. Int. J. Environ. Res. Public Health 2017, 14, 94. [Google Scholar] [CrossRef]
- Ojuederie, O.B.; Babalola, O.O. Microbial and plant-assisted bioremediation of heavy metal polluted environments: A review. Int. J. Environ. Res. Public Health 2017, 14, 1504. [Google Scholar] [CrossRef] [Green Version]
- Blaylock, M.J. Field demonstrations of phytoremediation of lead-contaminated soils. Phytoremediation of contaminated soil and water. In Phytoremediation of Contaminated Soil and Water; CRC: Boca Raton, FL, USA, 2020; pp. 1–12. [Google Scholar]
- Coelho, M.S.; Sales-Mellado, M.M. Effects of substituting chia (Salvia hispanica L.) flour or seeds for wheat flour on the quality of the bread. LWT-Food Sci. Tech. 2015, 60, 729–736. [Google Scholar] [CrossRef] [Green Version]
- Vangronsveld., J.; Herzig, R.; Weyens, N.; Boulet, J.; Adriaensen, K.; Ruttens, A.; Thewys, T.; Vassilev, A.; Meers, E.; Nehnevajova, E.; et al. Phytoremediation of contaminated soils and groundwater: Lessons from the field. Environ. Sci. Pollut. Res. 2009, 16, 765–794. [Google Scholar] [CrossRef]
- Birch, L.; Bachofen, R. Complexing agents from microorganisms. Experientia 1990, 46, 827–834. [Google Scholar] [CrossRef]
- Fogarty, R.V.; Tobin, J.M. Fungal melanins and their interactions with metals. Enzym. Microb. Technol. 1996, 19, 311–317. [Google Scholar] [CrossRef]
- Ledin, M. Accumulation of metals by microorganisms—Processes and importance for soil systems. Earth Sci. Rev. 2000, 51, 1–31. [Google Scholar] [CrossRef]
- Levinskaite, L. Effect of heavy metals on the individual development of two fungi from the genus Penicillium. Biologija 2001, 1, 25–30. [Google Scholar]
- Liaquat, F.; Munis, M.F.H.; Haroon, U.; Arif, S.; Saqib, S.; Zaman, W.; Khan, A.R.; Shi, J.; Che, S.; Liu, Q. Evaluation of metal tolerance of fungal strains isolated from contaminated mining soil of Nanjing, China. Biology 2020, 9, 469. [Google Scholar] [CrossRef] [PubMed]
- Zafar, S.; Aqil, F.; Ahmad, I. Metal tolerance and biosorption potential of filamentous fungi isolated from metal contaminated agricultural soil. Bioresour. Technol. 2007, 98, 2557–2561. [Google Scholar] [CrossRef]
- Nelson, D.W.; Sommers, L. Total carbon, organic carbon, and organic matter. Methods Soil Anal. Part 2 Chem. Microbiol. Prop. 1983, 9, 539–579. [Google Scholar]
- McLean, E.O. Soil pH and lime requirement. Methods Soil Anal. Part 2 Chem. Microbiol. Prop. 1983, 9, 199–224. [Google Scholar]
- Estefan, G.; Sommer, R.; Ryan, J. Methods of soil, plant, and water analysis. Man. West Asia North Afr. Reg. 2013, 3, 7–211. [Google Scholar]
- Hakanson, L. An ecological risk index for aquatic pollution control. A sedimentological approach. Water Res. 1980, 14, 975–1001. [Google Scholar] [CrossRef]
- Faiz, Y.; Tufail, M.; Javed, M.T.; Chaudhry, M.M. Road dust pollution of Cd, Cu, Ni, Pb and Zn along Islamabad expressway, Pakistan. Microchem. J. 2009, 92, 186–192. [Google Scholar] [CrossRef]
- Muller, G. The heavy metal pollution of the sediments of Neckars and its tributary: A stocktaking. Chem. Zeit. 1981, 105, 157–164. [Google Scholar]
- Loska, K.; Wiechuła, D.; Korus, I. Metal contamination of farming soils affected by industry. Environ. Int. 2004, 30, 159–165. [Google Scholar] [CrossRef]
- Nemerow, N.L. Stream, Lake, Estuary, and Ocean Pollution; Van Nostrand Reinhold Publishing Co: New York, NY, USA, 1991. [Google Scholar]
- White, T.J.; Bruns, T.; Lee, S.J.W.T.; Taylor, J. Amplification and direct sequencing of fungal ribosomal RNA genes for phylogenetics. Methods Appl. Fluoresc. 1990, 18, 315–322. [Google Scholar]
- Iram, S.; Zaman, A.; Iqbal, Z.; Shabbir, R. Heavy metal tolerance of fungus isolated from soil contaminated with sewage and industrial wastewater. Pol. J. Environ. Stud. 2013, 22, 691–697. [Google Scholar]
- Fu, Y.Q.; Li, S.; Zhu, H.Y.; Jiang, R.; Yin, L.F. Biosorption of copper (II) from aqueous solution by mycelial pellets of Rhizopus oryzae. Afr. J. Biotech. 2012, 11, 1403–1411. [Google Scholar]
- Tiwari, S.; Singh, S.N.; Garg, S.K. Microbially enhanced phytoextraction of heavy-metal fly-ash amended soil. Commun. Soil Sci. Plant Anal. 2013, 44, 3161–3176. [Google Scholar] [CrossRef]
- Konetzka, W.A. Microbiology of metal transformations. In Microorganisms and Minerals; Marcel Dekker: New York, NY, USA, 1977; pp. 317–342. [Google Scholar]
- Zapotoczny, S.; Jurkiewicz, A.; Tylko, G.; Anielska, T.; Turnau, K. Accumulation of copper by Acremonium pinkertoniae, a fungus isolated from industrial wastes. Microbiol. Res. 2007, 162, 219–228. [Google Scholar] [CrossRef]
- Samuel, A.D.; Tit, D.M.; Melinte, C.E.; Iovan, C.; Purza, L.; Gitea, M.; Bungau, S. Enzymological and physicochemical evaluation of the effects of soil management practices. Rev. Chim. 2017, 68, 2243–2247. [Google Scholar] [CrossRef]
- Samuel, A.D.; Brejea, R.; Domuta, C.; Bungau, S.; Cenusa, N.; Tit, D.M. Enzymatic indicators of soil quality. J. Environ. Prot. Ecol. 2017, 18, 871–878. [Google Scholar]
- Farhan, S.N.; Khadom, A.A. Biosorption of heavy metals from aqueous solutions by Saccharomyces cerevisiae. Int. J. Ind. Chem. 2015, 6, 119–130. [Google Scholar] [CrossRef] [Green Version]
- Puig, S.; Thiele, D.J. Molecular mechanisms of copper uptake and distribution. Curr. Opin. Chem. Biol. 2002, 6, 171–180. [Google Scholar] [CrossRef]
- Tu, C.; Liu, Y.; Wei, J.; Li, L.; Scheckel, K.G.; Luo, Y. Characterization and mechanism of copper biosorption by a highly copper-resistant fungal strain isolated from copper-polluted acidic orchard soil. Environ. Sci. Pollut. Res. 2018, 25, 24965–24974. [Google Scholar] [CrossRef] [PubMed]
- Behl, T.; Kaur, I.; Sehgal, A.; Singh, S.; Sharma, N.; Bhatia, S.; Al-Harrasi, A.; Bungau, S. The dichotomy of nanotechnology as the cutting edge of agriculture: Nano-farming as an asset versus nanotoxicity. Chemosphere 2022, 288, 132533. [Google Scholar] [CrossRef] [PubMed]
- Kowshik, M.; Nazareth, S. Metal tolerance of Fusarium solani. Ecol. Environ. Conserv. 2000, 6, 391–395. [Google Scholar]
Publisher’s Note: MDPI stays neutral with regard to jurisdictional claims in published maps and institutional affiliations. |
© 2022 by the authors. Licensee MDPI, Basel, Switzerland. This article is an open access article distributed under the terms and conditions of the Creative Commons Attribution (CC BY) license (https://creativecommons.org/licenses/by/4.0/).